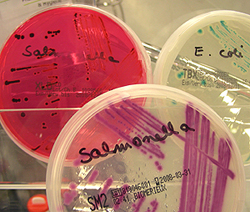

Die Anzahl lebensmittelbedingter Krankheitsausbrüche in der Schweiz hat auf tiefem Niveau eingependelt gemäss dem Schweizer Zoonosenbericht 2011 des Bundesamtes für Veterinärwesen.
|
Im Jahr 2011 wurden in der Schweiz nur sieben
lebensmittelbedingte Gruppenerkrankungen
erfasst, wobei in fünf Fällen ein kausales Agens
ermittelt werden konnte. Zwei Ausbrüche mit
Beteiligung von Salmonella Bardo und Listeria
monocytogenes zogen umfangreichere epidemiologische
Abklärungen nach sich.
Im Jahr 2011 wurden in der Schweiz nur sieben
lebensmittelbedingte Gruppenerkrankungen
erfasst, wobei in fünf Fällen ein kausales Agens
ermittelt werden konnte. Zwei Ausbrüche mit
Beteiligung von Salmonella Bardo und Listeria
monocytogenes zogen umfangreichere epidemiologische
Abklärungen nach sich.
Bei vier
Ausbrüchen waren Restaurants und ähnliche
Einrichtungen betroffen, in zwei Fällen führten
Produkte vom Markt zu Infektionen und
bei einem Ereignis mit Shigella sonnei konnten
mangels Daten keine Aussagen gemacht werden.
In vier von sieben Fällen wurden Mängel
in der Verarbeitungshygiene und fehlerhafte
Produktlagerung (Zeit-Temperatur-Fehler) als
Schwachpunkte identifiziert. Bis auf zwei Ausbrüche
mit 90 und 18 Fällen waren in der Regel
wenig Personen betroffen.
Erstmals wurde
kein durch Enterotoxine von Staphylokokken
bedingter Ausbruch registriert. In den letzten
Jahren hat sich die Zahl der Ausbrüche auf
tiefem Niveau stabilisiert, eine Entwicklung,
die sich 2011 erfreulicherweise fortsetzte.
Aktuelle Ausbrüche durch verschiedene
Erreger
Sporadische Fälle von Salmonellose haben in der
Schweiz mit 1206 Fällen im Jahr 2011 ein tiefes
Niveau erreicht, und Ausbrüche mit diesen Erregern
sind auch selten geworden. Seit Mai 2011
registrierte das Meldesystemdes BAG jedoch eine
Häufung von Fällen mit Salmonella Bardo, die
sich bis Ende Jahr fortsetzte. Dieser seltene Serovar
trat in der Schweiz zuvor nie auf, was darauf
hindeutete, dass im Mai 2011 ein erstmaliger Eintrag
in die Lebensmittelkette erfolgt sein muss.
Dass ein Ausbruch vorliegt, machten auch Untersuchungen
mit Pulsed-field Gel Electrophoresis
(PFGE) am Nationalen Referenzzentrum für enteropathogene
Bakterien und Listerien (NENT) deutlich.
Die Ergebnisse der molekularen Typisierung
zeigten, dass alle getesteten Isolate
demselben PFGE-Typ angehören.
Die Verteilung
der Krankheitsfälle liess auch den Schluss zu,
dass die Infektionen mit grösster Wahrscheinlichkeit
durch ein kommerziell vertriebenes Lebensmittel
ausgelöst wurden. Epidemiologische
Abklärungen (Patientenbefragungen und Auswertungen
von Kundenkarten) erlaubten es leider
nicht, die Infektionsquelle zu identifizieren.
Durch L. monocytogenes verursachte Ausbrüche
haben sich in der Schweiz seit 1987 erst zweimal
ereignet, wobei in beiden Fällen Weichkäse
beteiligt war. Im Jahr 2011 kam nun ein weiterer
Ausbruch mit neun betroffenen Patienten dazu.
Umfangreiche Abklärungen erlaubten es, aus
Italien importierten Kochschinken als Infektionsquelle
zu eruieren. Abklärungen im Produktionsland
selber ergaben, dass das betroffene
Produkt nicht beim Hersteller kontaminiert
wurde, sondern in einem Betrieb, welcher die
Ware zugeschnitten und verpackt hatte.
Bakteriologische
Analysen in der Schweiz zeigten,
dass das betroffene Produkt bis zu 4800 KBE pro
Gramm Listeria monocytogenes enthielt. Die Gesamtheit
der Befunde zu diesem Ausbruch soll
in einer wissenschaftlichen Publikation veröffentlicht
werden.
Pro Jahr werden dem BAG zwischen 150 und
250 Fälle von Shigellose gemeldet, die zumgrössten
Teil Reiseerkrankungen sein dürften. Ausbrüche
sind in der Schweiz sehr selten. Als Überträger
kommen hauptsächlich schmutzigesTrinkwasser
und durch Ausscheider kontaminierte Lebensmittel
infrage.
Im Berichtsjahr 2011 ereignete sich
in Genf ein lokal begrenzter Ausbruch von fünf
Shigella sonnei-Infektionen, wobei die durchgeführten
Abklärungen die Infektionsquelle nicht
mit Sicherheit identifizieren konnten. Bemerkenswert
war, dass die S. sonnei-Isolate eine Antibiotikaresistenz
des Typs ESBL aufwiesen.
Noroviren werden hauptsächlich von Person
zu Person übertragen (Infektionen via Aerosole
oder Kontakte). Möglich sind jedoch auch Infektionen
durch Lebensmittel, welche durch einen
Ausscheider kontaminiert worden sind. Leider
ist eine entsprechende Beweisführung oft nur
schwer möglich. Im Jahr 2011 wurde ein Ausbruch
mit Beteiligung von Noroviren erfasst,
dessen Charakteristika auf eine mögliche Infektion
durch Verpflegung eines Cateringbetriebes
hindeuten.
Bei zwei Ausbrüchen in Restaurants mit sieben
bzw. 18 betroffenen Personen konnte die Ursache
nicht ermittelt werden. Das Auftreten der Symptome
nach einigen Stunden wies jedoch unzweifelhaft
darauf hin, dass Intoxikationen vorlagen
und keine Infektionen. In den betroffenen Gaststätten
wurden bei der Herstellung der als
Überträger verdächtigten Speisen küchentechnische
Mängel festgestellt.
Schliesslich ereignete sich auch ein kleiner
Ausbruch von Histaminvergiftung bei Restaurantgästen.
Wie fast immer in solchen Fällenwar
ein Thunfischerzeugnis beteiligt. Bei Histaminvergiftungen
dürfte es zweifellos eine gewisse
Dunkelziffer geben.
Darauf deuten auch Einzelmeldungen
von Konsumenten hin, die definitionsgemäss
nicht als Ausbruch gelten, aber doch
Hinweise auf ein vorliegendes Problem sind. Im
Jahr 2011 wurden uns zwei solcher Einzelmeldungen
aus demKanton Tessin zugetragen.
Ausblick
Die Anzahl lebensmittelbedingter Krankheitsausbrüche
in der Schweiz hat sich seit einiger
Zeit auf einem tiefen Niveau eingependelt, ein
Trend, der sich auch im Jahr 2011 bestätigte. Es
gibt keine Anzeichen, dass sich an dieser gesamthaft
zufriedenstellenden Situation in naher Zukunft
etwas ändern wird.
Ein Nullrisiko gibt es
allerdings nicht, und es muss darum auch in
Ländern mit hohen Sicherheitsstandards immer
damit gerechnet werden, dass sich sporadisch
ein Ausbruch mit grossen Auswirkungen ereignet.
Die medienwirksame EHEC-Epidemie im
Sommer 2011 in Deutschland hat dies in eindrücklicherWeise
deutlich gemacht.
Obschon nicht direkt betroffen, hat dieser
Ausbruch die zuständigen Stellen in unserem
Land über längere Zeit stark in Anspruch genommen.
Ungleich grösser wäre die Beanspruchung
bei direkter Betroffenheit gewesen. Aus
diesem Grund ist es wichtig, dass die Kompetenzen
im Bereich Ausbruchsabklärung aufrechterhalten
werden, dass die Aufmerksamkeit nicht
nachlässt und dass grenzüberschreitende Fachkontakte
aktiv gepflegt werden.
(Auszug aus dem Schweizer Zoonosenbericht 2011 des Bundesamtes für Veterinärwesen
BVET). http://www.bvet.admin.ch/dokumentation/ 00327/02466/04107/index.html?lang=de
(gb)
|
__________________________________________
|
9.2.2016
|
| Wenn das Essen die Gene verändert |
Mütter beeinflussen mit ihrer Ernährung den Fett- und Zuckerstoffwechsel der
Nachkommen durch epigenetische Veränderungen.
weiter...
|
8.2.2016
|
| KURZNEWS 8. Februar 2016 |
Olivenöl-Preise um 20 Prozent gestiegen /
Desinfektionsmittelrückstände in Lebensmitteln nachgewiesen /
23 Mio. Europäer pro Jahr erleiden Lebensmittel-Infektionen
weiter...
|
4.2.2016
|
| KURZNEWS 4. Februar 2016 |
Micarna-Gruppe übernimmt Gabriel Fleury SA /
Tête de Moine erhält eigenes Fest /
Weichmacher fördern Übergewicht
weiter...
|
2.2.2016
|
| KURZNEWS 2. Februar 2016 |
Lidl steigert Export von Schweizer Lebensmitteln /
Täuschungen mit geschützten Bezeichnungen GUB / GGA /
Zu viel Milch produziert /
Warum schützt Rohmilch vor Allergien und Asthma?
weiter...
|
1.2.2016
|
| Schwieriges 2015 für Schweizer Käseexporte |
Der geringe Käseexportzuwachs von +0.3% im 2015 wurde dank einer Exportsteigerung ausserhalb der EU erzielt. Mengenmässig wurde 1.5% weniger in die EU exportiert.
weiter...
|
| 28.1.2016 | Hopfenextrakt als natürliches Konservierungsmittel
|
| 26.1.2016 | KURZNEWS 26. Januar 2016
|
| 21.1.2016 | Regelmässiges Streicheln beschleunigt Kälbermast
|
| 19.1.2016 | KURZNEWS 19. Januar 2016
|
| 18.1.2016 | Migros mit stabilem Umsatz im 2015
|
| 14.1.2016 | Wurstwaren wegen Deklarationsmängeln beanstandet
|
| 12.1.2016 | KURZNEWS 12. Januar 2016
|
| 8.1.2016 | Coop im 2015 mit weniger Umsatz
|
| 6.1.2016 | KURZNEWS 6. Januar 2016
|
| 5.1.2016 | Kaffee wirkt entzündungshemmend und zellschützend
|
| 30.12.2015 | fial gegen Nahrungsmittel-Spekulation-Initiative
|
| 28.12.2015 | KURZNEWS 28. Dezember 2015
|
| 24.12.2015 | KURZNEWS 24. Dezember 2015
|
| 22.12.2015 | Alternativen zum abzuschaffenden Schoggigesetz
|
| 17.12.2015 | KURZNEWS 17. Dezember 2015
|
| 15.12.2015 | KURZNEWS 15. Dezember 2015
|
| 8.12.2015 | KURZNEWS 8. Dezember 2015
|
| 3.12.2015 | KURZNEWS 3. Dezember 2015
|
| 1.12.2015 | KURZNEWS 1. Dezember 2015
|
| 30.11.2015 | Offiziell beste Jung-Metzgerin: Manuel Riedweg
|
| 26.11.2015 | KURZNEWS 26. November 2015
|
| 24.11.2015 | Ernst Sutter: offiziell beste Schweizer Metzgerei
|
| 19.11.2015 | KURZNEWS 19. November 2015
|
| 17.11.2015 | KURZNEWS 17. November 2015
|
| 11.11.2015 | Erforscht: Zartheit von vakuum-gegartem Fleisch
|